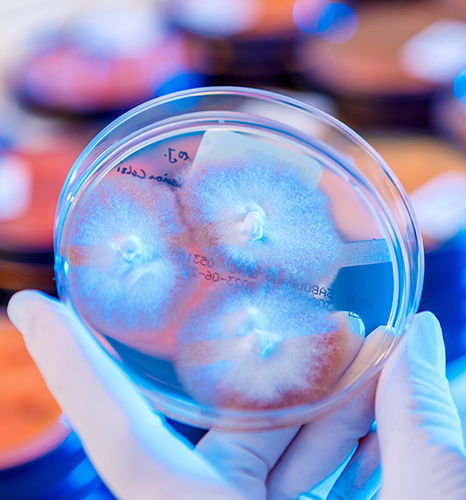
None

Medizinische Mykologie
Eine fundierte laboratoriumsdiagnostische Untersuchung bei Bedarf inkl. fachgerechter Materialentnahme mit daraus folgender Therapieempfehlung an den überweisenden Arzt erfolgt u. a. für diese Erreger-bedingten Krankheitsbilder (Infektionen der Haut- und Schleimhaut sowie Nägel):
- Pilzinfektionen der Haut und Nägel sowie Haare,
- Differenzierte Labordiagnostik bei Nagelpilz bzw. Onychomykose, insbesondere zur Abgrenzung anderer Nagelerkrankung (Onychodystrophie, Psoriasis unguium),
- Hartnäckige Infektionen der Haut durch Hautpilze (Dermatophyten), jedoch auch Hefepilze (Candida) sowie seltene Pilze,
- Erreger-bedingte, Therapie-refraktäre Hauterkrankungen,
- Haut- und Schleimhautinfektionen der Haut durch bakterielle, virale und parasitäre Erreger,
- Genitale Entzündungen der Frau (vaginale Mykosen, bakterielle Vaginose, genitaler Herpes, entzündliche genitale Erkrankungen) und des Mannes (Balanitis, Urethritis),
- Geschlechtskrankheiten,
- Reise- und Tropendermatosen
Publikationen
Pilzgalerie
Spezialsprechstunde bei Prof. Dr. med. habil. Pietro Nenoff
Termine nach Vereinbarung
Privatpatienten können uneingeschränkt diagnostiziert und behandelt werden.
Gesetzlich Versicherte benötigen einen speziellen Laborüberweisungsschein (Muster 10, Überweisung zum „Facharzt für Laboratoriumsmedizin“), ausgestellt vom Haus- oder Facharzt.